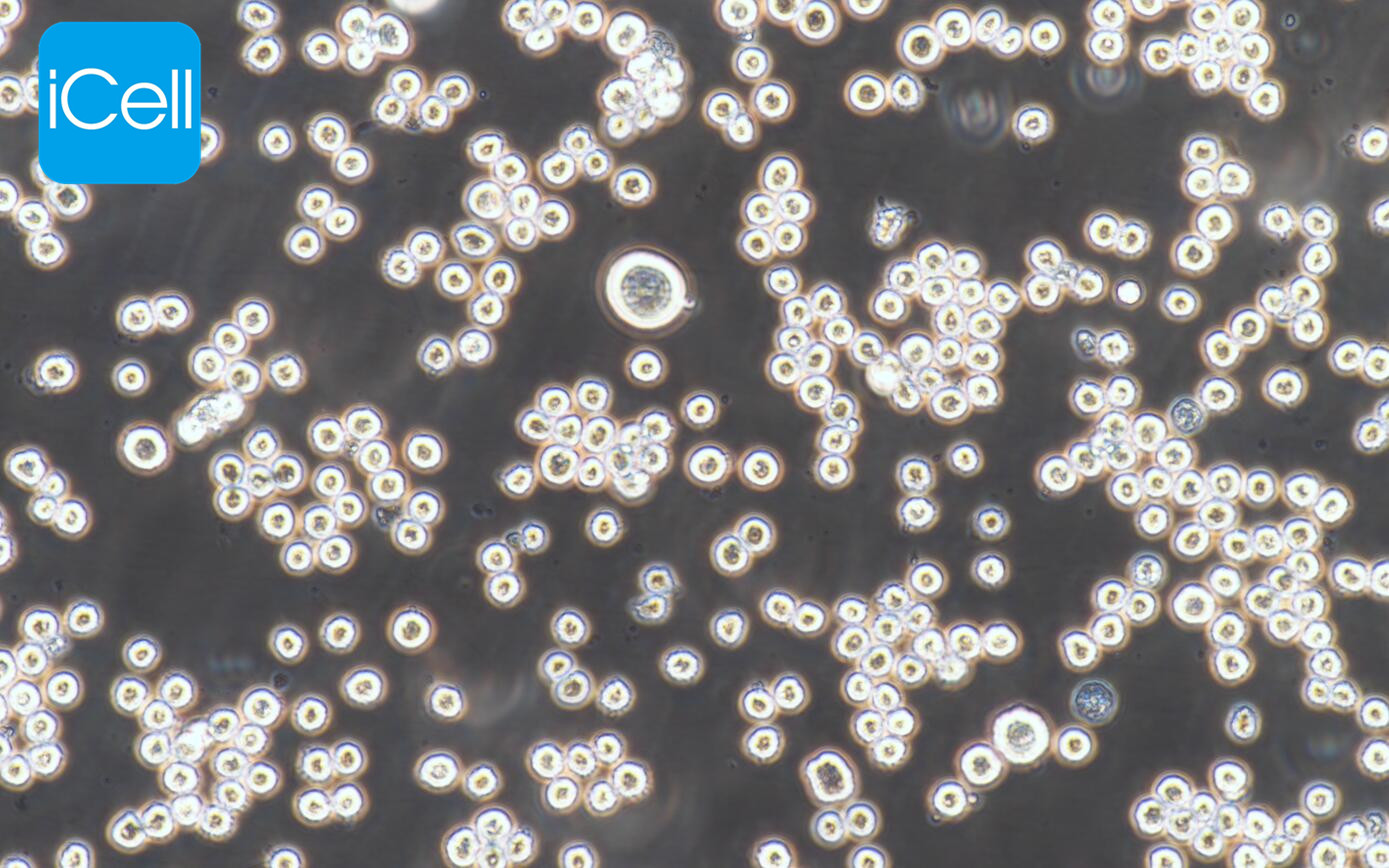
K562细胞/K-562细胞/K-562/K562/人慢性骨髓性白血病细胞系

K562细胞/K-562细胞/K-562/K562/人慢性骨髓性白血病细胞系
产品名称: K562细胞/K-562细胞/K-562/K562/人慢性骨髓性白血病细胞系
英文名称: K562 K-562
产品编号: iCell-h118
产品价格: 1350
产品产地: 上海
品牌商标: iCell
更新时间: 2025-11-11T15:42:41
使用范围: null
- 联系人 : 赵益隆
- 地址 : 上海市奉贤区茂园路260号临港南桥科技城56号楼7层
- 邮编 :
- 所在区域 : 上海
- 电话 : 186****3861 点击查看
- 传真 : 点击查看
- 邮箱 : 2695109861@qq.com
细胞介绍
该细胞是由Lozzio从一名53岁的慢性髓细胞性白血病急变期的女性患者的胸水中分离建立的。该细胞曾被认为来源于粒系,处于高度未分化阶段;Anderson等人作了细胞膜特性的研究后,认为该细胞是红白血病细胞系。该细胞是对自然杀伤细胞高度敏感的体外靶标,故而被广泛应用于这方面的研究。K562的原始细胞是一种具有多向分化潜能的造血系统的恶性肿瘤细胞,能自发分化为红系、粒系和单核系的可辨识的祖细胞。该细胞表达CD7(25%)。
细胞特性
1) 来源:骨髓
2) 形态:淋巴母细胞样;圆形,悬浮生长
3) 含量:>1x10^6 细胞数
4) 规格:T25瓶或者1mL冻存管包装
5) 用途:仅供科研使用。
运输和保存
干冰运输及复苏好存活细胞
(1)1mL冻存管包装干冰运输,收到后-80度冰箱保存过夜后转入液氮或直接复苏,若发现干冰已挥发干净、冻存管瓶盖脱落、破损及细胞有污染,请立即与我们联系。
(2)T25瓶复苏的存活细胞常温发货,收到后按照细胞接收后的处理方法操作。
细胞接收后的处理
1) 收到细胞后,75%酒精消毒瓶壁将T25瓶置于37℃培养箱放置约2-3h,若发现培养瓶破损、有液溢出及细胞有污染,请拍照后及时联系我们。
2)请在4或5X显微镜下确认细胞状态,同时给刚收到的细胞拍照(10×,20×)各2-3张以及培养瓶外观照片一张留存,作为售后时收到时细胞状态的依据。
3) 悬浮细胞:T25瓶置于37℃培养箱放置约2-3h,然后抽出瓶中的培养基和细胞1000rpm离心5分钟,弃去上清重悬后接种到新的培养瓶中(加入按照说明书细胞培养条件新配制的完全培养基)。
4)备注:运输用的培养基(灌液培养基)不能再用来培养细胞,请换用按照说明书细胞培养条件新配制的完全培养基来培养细胞。 收到细胞后第一次传代建议T25培养瓶1:2传代 。
一.培养基及培养冻存条件准备:
1) 准备IMDM(推荐iCell-0008)培养基;优质胎牛血清,10%;双抗,1%。
2) 培养条件: 气相:空气,95%;二氧化碳,5%。 温度:37摄氏度,培养箱湿度为70%-80%。
3) 冻存液:90%血清,10%DMSO,现用现配。
二. 细胞处理:
1) 冻存细胞的复苏:
将含有1mL细胞悬液的冻存管在37℃水浴中迅速摇晃解冻,加入到含4-6mL完全培养基的离心管中混合均匀。在1000RPM条件下离心3-5min,弃去上清液,完全培养基重悬细胞。然后将细胞悬液加入含6-8ml完全培养基的培养瓶(或皿)中37℃培养过夜。第二天显微镜下观察细胞生长情况和细胞密度。
2) 细胞传代:如果细胞密度达80%-90%,即可进行传代培养。
对于悬浮细胞,传代可参考以下方法:
悬浮状态下生长的细胞,可以通过向培养瓶中添加完全培养基来维持细胞的生长状态,一般情况下细胞密度维持在1×105~1×10^6个/mL(不同细胞对密度要求不同,)可以维持细胞的正常生长。如需分瓶可以将细胞悬液收集到离心管中1000rpm,离心5min,弃去上清,补加1-2mL培养液后重悬混匀后将细胞悬液按1:2的比例分到新T25瓶中,添加6-8ml按照说明书要求配置的新的完全培养基以保持细胞的生长活力,后续传代根据实际情况按1:2~1:5的比例进行。
3) 细胞冻存: 收到细胞后建议在培养前3代时冻存一批细胞种子以备后续实验使用。
下面T25瓶为例;
1. 细胞冻存时按照细胞传代的过程收集消化好的细胞到离心管中,可使用血球计数板计数,来决定细胞的冻存密度。一般细胞的推荐冻存密度为1×10^6~1×10^7个活细胞/ml.
2. 1000rpm离心3-5min,去掉上清。用配制好的细胞冻存液重悬细胞 ,按每1ml冻存液含1×10^6~1×10^7个活细胞/ml分配到一个冻存管中将细胞分配到冻存管中,标注好名称、代数、日期等信息。
3. 将要冻存的细胞置于程序降温盒中,-80度冰箱中过夜,之后转入液氮容器中储存。同时记录好冻存管在液氮容器中的位置以便后续查阅和使用。
